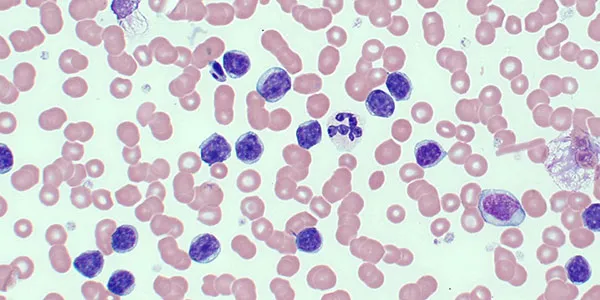

AlmaMedix
Where Accuracy matters
Our History Since 2006, our team, leveraging years of prior experience in the field of in vitro diagnostics (IVD), has been committed to supporting the global IVD community
In vitro Diagnostics
AlmaMedix offers to the clinical laboratory professionals a wide range of IVD reagents and analyzers spanning from clinical chemistry to coagulation, from bacteriology to serology manufactured according to high quality standards.
Why choose us?
AlmaMedix offers to the clinical laboratory professionals a wide range of IVD reagents and analyzers spanning from clinical chemistry to coagulation, from bacteriology to serology manufactured according to high quality standards.
- Advanced Analytical Performance AlmaMedix diagnostic assays and kits are developed to deliver high sensitivity, specificity, and precision, meeting the rigorous demands of modern clinical laboratories.
- Customized Diagnostic Solutions AlmaMedix offers flexible OEM and private-label services, providing tailored diagnostic solutions adapted to specific laboratory and industrial requirements.
- Reliable Global Support Through a growing distribution network and dedicated scientific support, AlmaMedix ensures effective implementation and optimal performance of its diagnostic solutions worldwide.
- Scientific Excellence & Continuous Innovation Research and development at AlmaMedix are guided by advanced scientific methodologies and modern technologies, supporting continuous progress across clinical chemistry, immunochemistry, coagulation, hematology, and microbiology.
- Quality & Standards Compliance All AlmaMedix products are designed and manufactured in accordance with ISO 13485 and other applicable quality standards, ensuring high levels of accuracy, reproducibility, and reliability.
- Integrated Manufacturing & Process Control AlmaMedix maintains full control over the entire production chain, from raw material selection to final quality control, guaranteeing consistency and stability across all production batches
Choose the Best Products
and Get the Best Results
The Science Behind Quality Diagnostics
In in vitro diagnostics (IVD), the selection of high-quality products directly influences the accuracy, reliability, and clinical utility of laboratory results. At AlmaMedix Diagnostics International GmbH, we ensure that our diagnostic solutions meet the highest standards of analytical performance and regulatory compliance, offering laboratories and healthcare professionals the confidence they need for patient care.
Why Product Quality Matters in Diagnostics?
- Analytical Sensitivity & Specificity
- A superior diagnostic product must provide precise detection of analytes, minimizing false positives and negatives.
- High signal-to-noise ratios and optimized reaction kinetics ensure accuracy, even at low analyte concentrations.
- Reproducibility & Stability
- Consistency across multiple measurements is critical in laboratory medicine.
- Our products undergo stringent lot-to-lot validation, ensuring reliability across different batches.
- Stability studies, including real-time and accelerated aging, guarantee extended shelf life and robust performance.
- Regulatory Compliance & Quality Assurance
- All AlmaMedix products are manufactured under ISO 13485
- Validation studies confirm precision, linearity, limit of detection (LoD), limit of quantification (LoQ), and robustness before market release.
- Integration & Efficiency in Clinical Workflow
- Compatibility with automated and semi-automated analyzers enhances lab efficiency.
- Reduction of turnaround time (TAT) without compromising accuracy allows for optimized patient management.
- Customization & Advanced Technological Platforms
- From clinical chemistry to coagulation, immunochemistry, and serology, we develop tailor-made OEM and private-label solutions to meet diverse laboratory needs.
- Our R&D-driven approach ensures continuous innovation in biomarker, molecular diagnostics, and point-of-care testing (POCT).